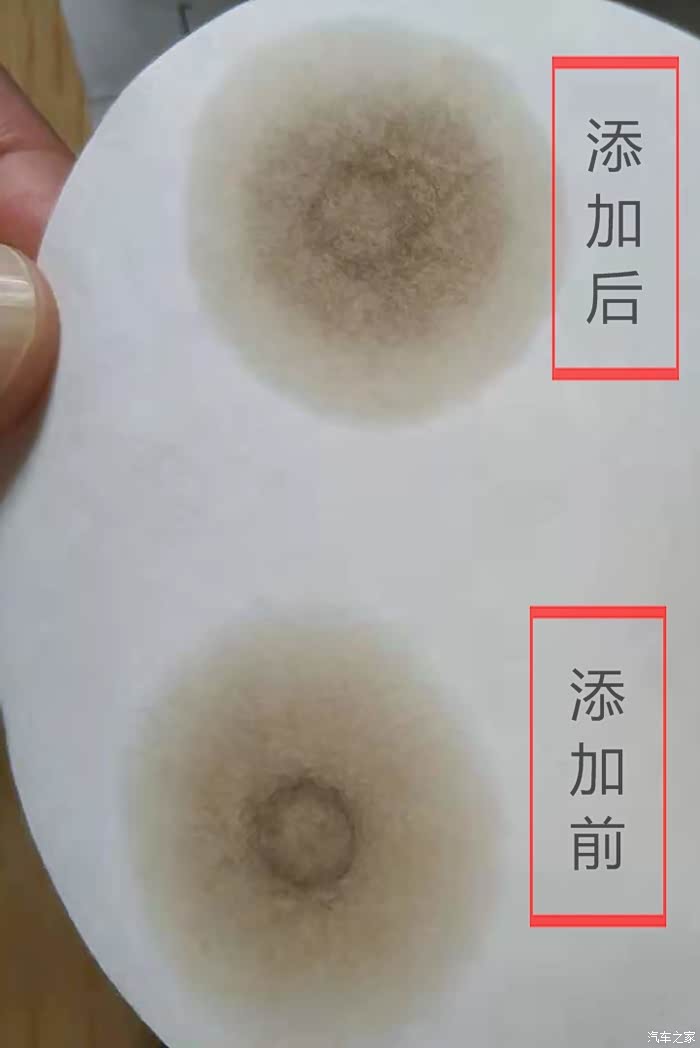
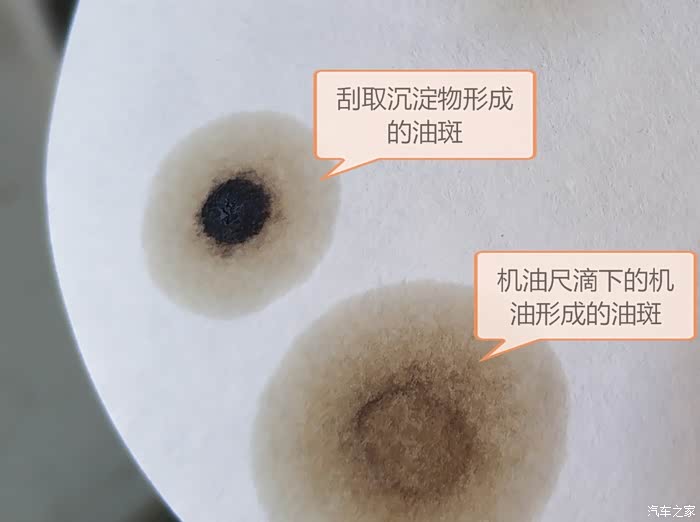

热门
说PEA不污染机油的来看看

背景:6年7.8万公里的自吸车,在火花塞、节气门等其他保养都正常进行的前提下,感受到提速肉,因此尝试添加燃油宝(有效成为为PEA)按照客服说明减量分多次添加,累计添加了1瓶,添加后累计行驶约1000公里。机油是AFE0w20,2019年11月产(就是用GTL替代了部分PAO的那一批),8个月,路况短途为主,急加速较多,但转速很少超过3000转。加入燃油宝之前累计行驶约6000公里,更换机油时累积行驶7147公里。
问题:因为加入燃油宝后感觉抖动增加,油耗明显增加,产品介绍上已提前说明这些症状正常。测试机油油样发现沉积环污染较多,遂打开机油加注口观察,发现黑色颗粒状沉淀物。持续观察记录、形成此文,供参考。
声明:本文用意仅表明燃油宝对机油有污染,燃油宝总部技术人员答复:该污染物为溶解下的积碳等通过活塞环和气缸间隙进入到机油中,呈泥状、软、带有极性易附着,但不会造成发动机磨损。下一瓶我还是等快更换机油之前再加,以免过早的污染机油或者提前换油造成浪费。
问题:因为加入燃油宝后感觉抖动增加,油耗明显增加,产品介绍上已提前说明这些症状正常。测试机油油样发现沉积环污染较多,遂打开机油加注口观察,发现黑色颗粒状沉淀物。持续观察记录、形成此文,供参考。
声明:本文用意仅表明燃油宝对机油有污染,燃油宝总部技术人员答复:该污染物为溶解下的积碳等通过活塞环和气缸间隙进入到机油中,呈泥状、软、带有极性易附着,但不会造成发动机磨损。下一瓶我还是等快更换机油之前再加,以免过早的污染机油或者提前换油造成浪费。

此油样为添加燃油宝之前的快速滤纸约4小时油样。AFE 0W20(掺了上次剩的约300ml纯牌5W20)合计3L,自然吸气,市区短途为主,约6000公里。6万公里首次使用AFE,首次观察到了沉积环,但是竟然是中空的,百思不得其解。以前用过长城吉吉、pp、纯牌,都未见过明显的沉积环。
添加燃油宝行驶一段路程后,发现油样明显发黑,怀疑燃油宝对机油产生了污染。

观察机油加注口,发现正时机构的铁件、铝质发动机壳的内壁、黄色的挡板上,都出现了明显的黑色颗粒状沉淀物。

正时机构的铁件的黑色颗粒状沉淀物。

机油尺上附着的机油里有黑色颗粒状沉淀物。熄火10分钟、熄火1小时,都是这样的结果。刚刚熄火时看上去比较均匀暗黄但是透明,看不到明显的沉淀。
用机油尺多次刮取沉淀物,集中粘到滤纸上,静置3小时形成的油斑,中间的沉淀物大量堆积,已无法跟随机油进行扩散。对比直接从机油尺上滴下形成的油样,可以确定沉积环的黑色物质并不能溶解于目前状态下的机油。新机油是否可将其溶解尚未知,且看下文对比实验。

制作多个油样后,分别滴上新的机油(AFE0W20)、手动变速箱油(纯牌75W)。下文还会滴上该品牌燃油宝。

滴上新机油、变速箱油后,扩散环都明显淡化,但沉积环都没有明显变化。说明:1、机油对沉积物几乎没有分散能力。2、发动机内部的沉积物并非机油老化才形成的,因此尚不能判断燃油宝是否会加速机油的老化和对添加剂的消耗。3、燃油宝应该不会加速添加剂中的含钙镁的盐类等清洁分散剂的消耗。4、机油中的清洁分散剂未必能够分散这种沉积物。换用清洁效果更好的壳牌/pup/pp之类,恐怕也无法将发动机内的沉积物快速分解掉,由于未试验,此处抛出一个话题,希望有真实经验的网友给与解答。

在油样上滴上燃油宝,静置1小时,沉积物明显有被分散的痕迹!说明燃油宝可以去除这些黑色的沉淀物!但是**,我不敢把燃油宝直接从机油加注口倒进去清洗发动机,我不是小雄,也不准备说车,而且目前较贫困,没钱换车。

燃油宝可以分散黑色糊状沉淀物。

燃油宝可以分散黑色糊状沉淀物。

该燃油宝主要成分为PEA

这一锅机油一共行驶了7147公里。如果不是燃油宝造成的黑色沉淀物过多,我打算8000再换。

新机油换上跑了500公里了,今天才抽出时间把机滤锯开。WIX的机滤做工非常好,和原车电装的品质差不多,滤纸好像略薄一点点。当然薄厚不影响过滤效果。经历了大量沉积物的洗礼,滤纸未扭曲变形、未破裂,说明质量够用。

将机滤内壳中积累的沉积物倒出,确实很多。这些应该都是来自进气道、气门、气缸、活塞顶、喷油嘴、火花塞等位置的积碳。7万多公里,确实非常多。而且按照目前添加的量来判断,应该才洗下来一小部分。按照客服说的需要再添加1-2瓶才可以基本洗干净。

沉积物主要成分应该是碳。如果仅仅是碳,由于它的层状结构,倒是可以起到润滑效果,不会增加磨损。然而当然不可能是纯碳,里面肯定还有各种杂质。本地风大土多,虽然空气滤常清常换,但是小直径的灰尘依然会进入发动机,所以这些杂质里应该会含有微量的硅元素,这个是磨损的元凶之一。按照燃油宝官方技术人员的说法,这是从活塞环和气缸之间的间隙里窜入机油的,说明它们的直径非常小,不至于对发动机造成磨损。而且按照产品介绍的,该燃油宝最多3倍量添加使用也不会对发动机造成任何磨损,不知道这个说法是否可信呢。

真的是很多,我佩服我车的积碳能力和机滤的过滤能力!虽然我车是电喷自吸,而且我很少高档低速,没事喜欢拉拉高转速,但是毕竟短途为主,很少跑高速,所以积碳不会少。一位4S店技师说过,发动机只要运转,就不可避免积碳的产生,只是驾驶风格会影响积碳形成的速度,汽油品质和燃烧方式会影响积碳的量和成分。

题外话:弹簧强度、粗细、加工精度良好;止回阀(熄火后将机油保持在机滤中,以及防止机油倒流)的柔软度和密封效果都非常出色;旁通阀的加工精度良好,弹簧弹力较大,这样会让滤纸承受更大的压力,除非滤纸堵的非常厉害,否则决不让混合了杂质的机油不经过过滤直接从这里窜走。

更换新机油后已行驶500公里,沉积环仍然是中空的,这点很奇怪。

更换新机油后已行驶504.7公里
很抱歉,该主帖尚未满足精华帖15张图片要求,不能予以精华,更多精华标准点击此处查看
修改主帖
内容系网友发布,涉及安全和抄袭问题属于网友个人行为,不代表汽车之家观点,可联系客服删除。
举报
回复
 不至于吧,才5-6w公里就有动力衰减?我的也是丰田的致炫跟你的一样的,但是我的都已经跑了11.5w了,也没这种情况呀
不至于吧,才5-6w公里就有动力衰减?我的也是丰田的致炫跟你的一样的,但是我的都已经跑了11.5w了,也没这种情况呀 刚换的银美跑了不到2000公里,千三刚兑,岂不是完蛋了
刚换的银美跑了不到2000公里,千三刚兑,岂不是完蛋了
 游客
游客










